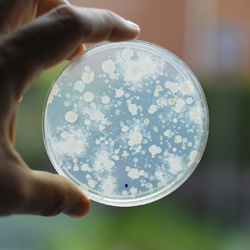

Mikrobiologinen tutkimus (STM 401/2001)
Tämä tutkimuspaketti on tarkoitettu kaikille talousvetenä käytettäville vesille. On tärkeää, ettei juomavesi sisällä sairauksia aiheuttavia bakteereita. Rengas- ja porakaivot ovat satunnaisesti alttiita pintavesien valunnalle ja erityisesti rengaskaivoissa voi esiintyä kolimuotoisia tai suolistoperäisiä bakteereja.

Mikrobiologinen tutkimus (STM 401/2001)
Jos talousvedessä esiintyvien bakteerien määrä ylittää sallitut raja-arvot, on syytä selvittää mistä mahdollinen kaivon likaantuminen johtuu, jotta kaivolle voidaan suorittaa tarvittavat kunnostus- ja puhdistustoimenpiteet.
Kaivoveden mikrobiologisen laadun osoittava tutkimuspaketti sisältää seuraavat analyysit sekä lausunnon veden laadusta.
Kaivovesinäyte tulee saapua laboratorioon vuorokauden sisällä näytteenotosta. Lue lisää tärkeää tietoa näytteen toimituksesta "Milloin näyte tulee toimittaa laboratorioon".
Tutkimuksen kesto: 7 päivää
Paketin sisältämät analyysit: Mikrobiologinen tutkimus (STM 401/2001)- Kolimuotoiset bakteerit
- Escherichia coli
- Enterokokit
- Mikrobiologinen tutkimus (STM 401/2001)

Rengaskaivovesitutkimus (STM 401/2001)
Tämä tutkimuspaketti on tarkoitettu rengaskaivoille. Tutkimus suositellaan tehtäväksi säännöllisin väliajoin käytössä oleville kaivoille ja erityisesti uusille kaivoille tai kun veden laadussa havaitaan muutoksia.


Rengaskaivovesitutkimus (STM 401/2001)
Rengaskaivoveden tutkimuspaketti sisältää seuraavat analyysit sekä lausunnon veden laadusta.
Kaivovesinäyte tulee saapua laboratorioon vuorokauden sisällä näytteenotosta. Lue lisää tärkeää tietoa näytteen toimituksesta "Milloin näyte tulee toimittaa laboratorioon".
Tutkimuksen kesto: 14 päivää
Paketin sisältämät analyysit: Rengaskaivovesitutkimus (STM 401/2001)- Enterokokit
- Kolimuotoiset bakteerit
- Escherichia coli
- pH
- CODMn/humus
- Sähkönjohtavuus
- Väriluku
- Kloridi
- Nitraatti
- Haju
- Ammonium
- Alkuaineanalyysi, johon kuuluu alla olevat tutkimukset
- Kovuus (Ca + Mg)
- Mangaani (Mn)
- Rauta (Fe)
- Alumiini (Al)
- Fluoridi
- Rengaskaivovesitutkimus (STM 401/2001)

Porakaivovesitutkimus (STM 401/2001)
Tämä tutkimuspaketti on tarkoitettu porakaivoille. Tutkimus suositellaan tehtäväksi säännöllisin väliajoin käytössä oleville kaivoille ja erityisesti uusille kaivoille tai kun veden laadussa havaitaan muutoksia.


Porakaivovesitutkimus (STM 401/2001)
Porakaivoveden tutkimuspaketti sisältää seuraavat analyysit sekä lausunnon veden laadusta.
Kaivovesinäyte tulee saapua laboratorioon vuorokauden sisällä näytteenotosta. Lue lisää tärkeää tietoa näytteen toimituksesta "Milloin näyte tulee toimittaa laboratorioon".
Tutkimuksen kesto: 14 päivää
Paketin sisältämät analyysit: Porakaivovesitutkimus (STM 401/2001)- Enterokokit
- Escherichia coli
- Kolimuotoiset bakteerit
- pH
- CODMn/humus
- Sähkönjohtavuus
- Väriluku
- Kloridi
- Fluoridi
- Radon
- Haju
- Alkuaineanalyysi, johon kuuluu alla olevat tutkimukset
- Kovuus (Ca + Mg)
- Mangaani (Mn)
- Uraani (U)
- Rauta (Fe)
- Arseeni (As)
- Porakaivovesitutkimus (STM 401/2001)
Toimitusmaksu
Toimitusmaksu on 20 € (sis. alv) sisältäen näytteenottoastioiden lähetyksen asiakkaalle ja näytteen lähetyskulut laboratorioon Postin pikapakettina (9-paketti). Huomioithan, että Eurofins Environment Testing Finland Oy ei vastaa Postin viivästyksistä. Varmistathan toimitusaikataulun käyttämästäsi postitoimipaikasta ennen tilauksen tekoa.

Yksittäiset analyysit
Lisää analyysejä kaivoveden tutkimiseen.

